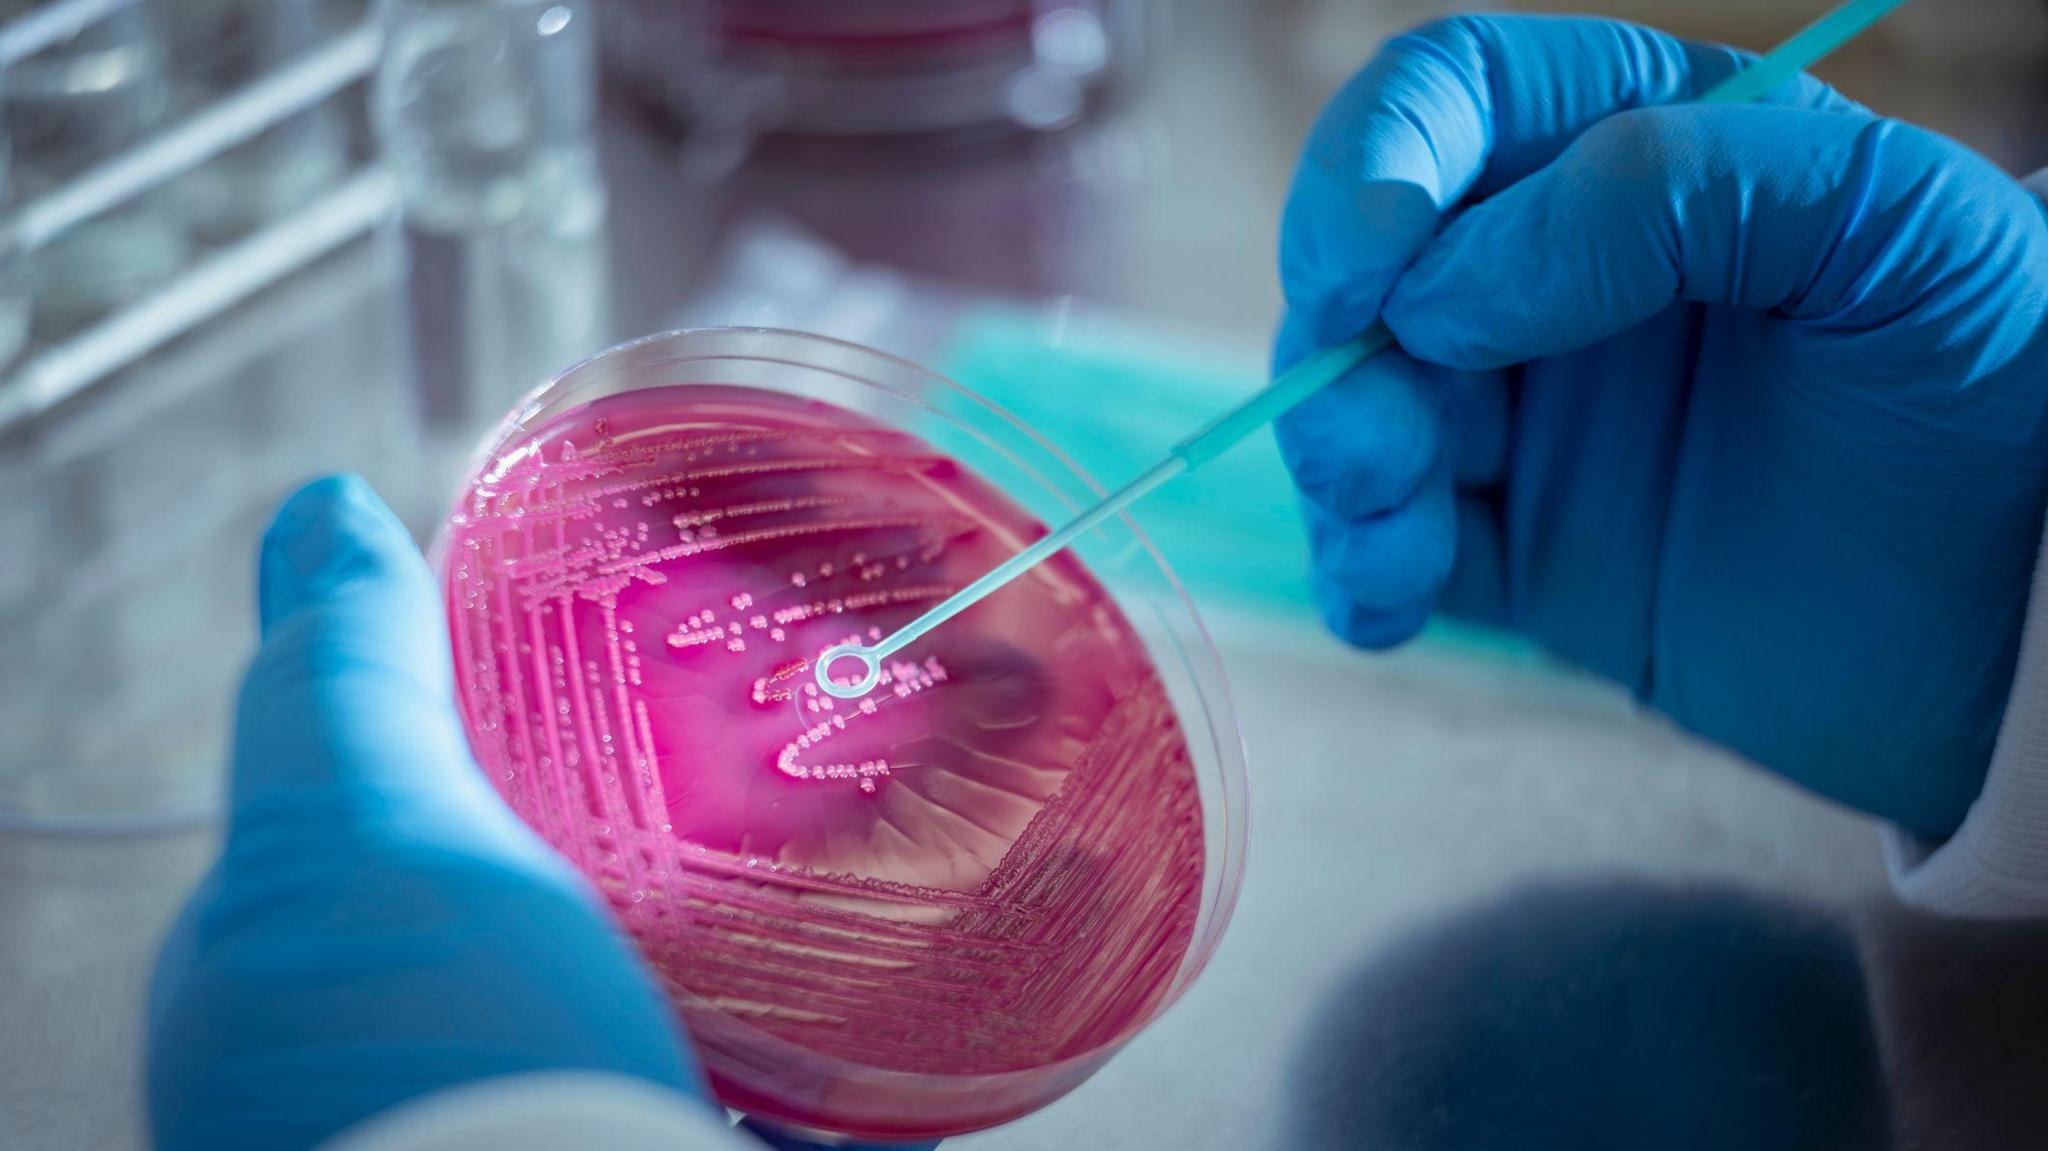
A petri dish filled with pink bacteria is being swabbed by a blue stick in a laboratory. The scientist is wearing blue gloves and a white lab coat.

Animal experiments to be phased out in the UK, says government

Tests on animals - like rabbits - could stop by the end of the year
- Published
The government has announced plans to stop scientific experiments on animals, except in some rare situations.
They say they want other testing methods to be used instead, including a greater use of artificial intelligence (AI), lab grown animal tissue and computer simulations.
The announcement has been welcomed by animal charity, the RSPCA, but it said the government must deliver on its promises.
So, when could we see the changes happen and what is animal testing? Read on to find out more...
What is animal testing?
- Published16 May 2023
UK bans animal testing for make-up ingredients
- Published20 May 2023
RSPCA pushes for tougher laws on animal welfare
- Published6 February 2020
When will animal testing stop?

The Labour Party made a manifesto commitment - or promise - to make sure animal testing was phased out when they were trying to win the election.
Now they are trying to make that promise come true.
By the end of this year they want to end tests on rabbits, where they are given a small dose of a new drug. The plan is to replace them by using human cells in a dish.
They are aiming to stop the use of animals for major safety tests by the end of 2025.
The government also wants to reduce the use of dogs and primates in human medicine tests by 35% by 2030.
However, we don't know if or when animal testing will be stopped completely.
Science Minister Lord Vallance told BBC News that he could imagine a day where the use of animals in science was almost completely phased out but acknowledged that it would take time.
What will animal testing be replaced with?

This organ-on-a-chip can be used in place of animals for some types of experiments
Scientists have been developing alternatives to animal testing for some time.
Researchers at Queen Mary University of London have created "organ-on-a-chip" technology.
That's where cells are collected from different parts of the body, like the liver or the brain, and are then connected to electrodes which sends the information to a computer.
Another alternative to animal testing is using artificial intelligence (AI) to predict whether new medicines will be safe and work well on humans.
Between 2026 and 2035, the government plans to speed up the use of non-animal techniques, including the organ-on-a-chip devices and artificial intelligence.
The RSPCA has cautiously welcomed the plan, describing it as a "significant step forward", but has urged the government to deliver.
Petri dishes are used to grow microorganisms like bacteria and cells
However, some scientists who work with animal experiments are not sure.
They feel like if changes are made too quickly, then it could have negative consequences for science and medicine.
Professor Robin Lovell-Badge, a scientist who has worked with animal experiments, said:
"How about the brain and behaviour? How can you study behaviour in a petri dish You just can't."
What is animal testing?
Nina explains animal testing (from 2023)
Animal testing is when living animals are used in scientific research to test their reactions to how effective a medicine is or how safe a product is for people.
Testing on animals in the UK is legal but only allowed if the benefits gained from the research outweighed any animal suffering, for example when used to test medicines.
The most common animals tested on are mice, birds, fish and rats.
Animal experiments in the UK peaked in 2015, falling to almost half by 2020, but since then that decline has slowed down.